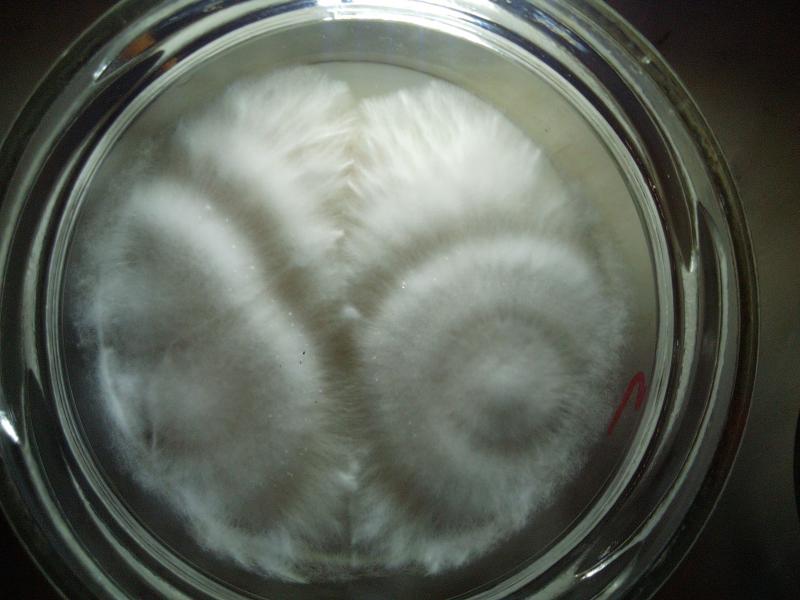

Bonjour, j’ai un petit souci avec mon premier kit il y a des champignons qui s’emmêlent si on peut dire je voulais savoir si il n’y avait pas de risque qu’il libère les spores plus tôt dans cette position ou si cela va créer d’autres problèmes. C’est sûrement une question bête, mais je préfère avoir votre avis. Merci d’avance bonne journée
Hors ligne

Hors ligne

sly31 a écrit
Bonjour, ton kit est bien de marque Zamnézia?
Oui c’est bien ça, excusez-moi je ne l’ai pas précisé
Hors ligne

C'était très bien de ne pas le préciser. Ca ne change rien de toute façon, et la charte interdit de citer les shops.
Pour ta question : tout est normal, l'enchevêtrement des champignons n'a rien à voir avec la libération des spores.
Pour éviter qu'ils ne lâchent leurs spores, il faut juste les cueillir au bon moment. Lorsque le voile sous le chapeau est à peine déchiré, comme sur ces photos trouvées sur le forum :

Hors ligne

Pesteux a écrit
C'était très bien de ne pas le préciser. Ca ne change rien de toute façon, et la charte interdit de citer les shops.
Pour ta question : tout est normal, l'enchevêtrement des champignons n'a rien à voir avec la libération des spores.
Pour éviter qu'ils ne lâchent leurs spores, il faut juste les cueillir au bon moment. Lorsque le voile sous le chapeau est à peine déchiré, comme sur ces photos trouvées sur le forum :
Image: https://www.psychoactif.org/forum/uploa … te---1.jpg
Image: https://www.psychoactif.org/forum/uploa … te---2.jpg
D’accord, excusez-moi c’est mon premier poste sur le forum. Merci beaucoup de m’éclairer à ce sujet. Je ne connaissais vraiment pas la culture de champi je trouve ça vraiment intéressant il y a tellement à apprendre.
Hors ligne


Pesteux a écrit
C'était très bien de ne pas le préciser. Ca ne change rien de toute façon, et la charte interdit de citer les shops.
Pour ta question : tout est normal, l'enchevêtrement des champignons n'a rien à voir avec la libération des spores.
Pour éviter qu'ils ne lâchent leurs spores, il faut juste les cueillir au bon moment. Lorsque le voile sous le chapeau est à peine déchiré, comme sur ces photos trouvées sur le forum :
Image: https://www.psychoactif.org/forum/uploa … te---1.jpg
Image: https://www.psychoactif.org/forum/uploa … te---2.jpg
Bonjour, ce matin je viens de m’apercevoir que seulement un Champi a le voile déchiré mais il est vraiment tout seul. Ça me paraît assez tôt pour les autres. Vous en pensez quoi ?
Hors ligne

Salut ! Il faut le récolter en vitesse, si tu ne veux pas qu'il lâche ses spores ! Une fois le voile déchiré, c'est imminent.
Arrivés à maturité, les champis changent très vite. En quelques heures, les voiles s'ouvrent, et les spores peuvent tomber. Pour récolter tous ses champis juste avant l'ouverture du chapeau, il faut les surveiller comme le lait sur le feu, vérifier plusieurs fois par jour, et faire plusieurs prélèvements dans la journée. Ca demande beaucoup d'attention, surtout si tu as plusieurs boxes.
Il y a donc deux façons de voir les choses :
Soit, tu veux récolter chaque champignon au moment optimal, et tu y consacres le temps nécessaire. Il faut avoir le temps disponible et la motivation pour ça. C'est comme ça que tu obtiendras le meilleur rendement en psilocybine par rapport à l'argent investi.
Soit, tu veux faire au plus simple, et tu récoltes tout au même moment, quitte à récolter un peu trop tôt. Tu perdras de la psilocybine, mais tu gagneras du temps. C'est comme ça que tu obtiendras le meilleur rendement en psilocybine par rapport au temps investi.
Tu peux aussi chercher un compromis. Par exemple, en faisant deux récoltes par flush. La première, tu prends seulement les plus gros, ensuite tu laisses pousser encore un peu les petits, et finalement, tu récoltes tout ce qui reste.
Dans tous les cas, essaye de récolter avant la sporulation, quitte à cueillir trop tôt. C'est plus facile pour identifier les contas, et ça réduit le risque pour les flushes suivantes.
Une petite présentation pour résumer :
Hors ligne

Pesteux a écrit
Salut ! Il faut le récolter en vitesse, si tu ne veux pas qu'il lâche ses spores ! Une fois le voile déchiré, c'est imminent.
Arrivés à maturité, les champis changent très vite. En quelques heures, les voiles s'ouvrent, et les spores peuvent tomber. Pour récolter tous ses champis juste avant l'ouverture du chapeau, il faut les surveiller comme le lait sur le feu, vérifier plusieurs fois par jour, et faire plusieurs prélèvements dans la journée. Ca demande beaucoup d'attention, surtout si tu as plusieurs boxes.
Il y a donc deux façons de voir les choses :
Soit, tu veux récolter chaque champignon au moment optimal, et tu y consacres le temps nécessaire. Il faut avoir le temps disponible et la motivation pour ça. C'est comme ça que tu obtiendras le meilleur rendement en psilocybine par rapport à l'argent investi.
Soit, tu veux faire au plus simple, et tu récoltes tout au même moment, quitte à récolter un peu trop tôt. Tu perdras de la psilocybine, mais tu gagneras du temps. C'est comme ça que tu obtiendras le meilleur rendement en psilocybine par rapport au temps investi.
Tu peux aussi chercher un compromis. Par exemple, en faisant deux récoltes par flush. La première, tu prends seulement les plus gros, ensuite tu laisses pousser encore un peu les petits, et finalement, tu récoltes tout ce qui reste.
Dans tous les cas, essaye de récolter avant la sporulation, quitte à cueillir trop tôt. C'est plus facile pour identifier les contas, et ça réduit le risque pour les flushes suivantes.
Une petite présentation pour résumer :
D’accord, merci beaucoup j’ai finalement tout récolté d’un coup 
J’ai eu un peu de mal, mais je m’organiserai mieux la prochaine fois. Je suis assez content pour une première fois je sais pas ce que vous en pensez.
Hors ligne


Hors ligne

Pesteux a écrit
Ca a l'air d'une bonne récolte
Elle pèse combien ?
Prend bien soin de la faire sécher correctement pour ne pas la gâcher.
Je ne l’ai pas pesé pour le moment, j’avais un peu peur de mal faire.
Vous pensez que je peux les laisser sécher dans le carton si je le mets à un endroit bien aéré ? Je peux les laisser le temps que je souhaite où il ne doivent pas être trop longtemps à l’air libre ? Merci beaucoup pour toutes vos réponses
Hors ligne

Salut !
Stresse pas, tu ne risques pas de faire de bêtise en pesant. Perso, j'adore peser à la fin d'une récolte, c'est un moment jouissif. Faut pas se priver de ce plaisir 
Il faut surtout éviter le contact prolongé entre les champignons et les matières plastiques. Mais le temps de peser, ça craint rien.
Oui, le carton dans un endroit bien aéré, ça devrait le faire. A l'abri de la lumière directe du soleil, c'est mieux.
Si t'as un ventilateur pour souffler dessus, c'est encore mieux.
Les premiers jours, une ou plusieurs couches de papier essuie-tout sous les champis devrait aider à absorber une partie de l'humidité par capillarité.
Si tu coupes les champignons longitudinalement, ça séchera plus vite, et tu pourras poster une photo pour vérifier qu'ils ne sont pas moisis à l'intérieur, comme on voit dans le lien ci-dessous.
https://www.psychoactif.org/forum/2023/ … .html#divx
C'est une bonne habitude de vérifier, mais t'inquiète pas hein, tout à l'air ok.
Tu peux les laisser sécher autant qu'il faut. Je dirais même "tu dois", car c'est très important pour bien les conserver. Sinon, ils risquent de moisir et de devenir inconsommables.
Un lien sur le séchage et l'homogénéisation d'une récolte. Mon post dans ce fil regroupe à peu près tout ce que je sais sur la question :
https://www.psychoactif.org/forum/2023/ … .html#divx
Amicalement.
PS : Tu peux me tutoyer hein ! C'est l'usage sur le forum. Ou alors je te vouvoie si tu préfères, mais ne restons pas dans ce déséquilibre, c'est un peu gênant 
Dernière modification par Pesteux (30 août 2023 à 10:09)
Hors ligne

Pesteux a écrit
Salut !
Stresse pas, tu ne risques pas de faire de bêtise en pesant. Perso, j'adore peser à la fin d'une récolte, c'est un moment jouissif. Faut pas se priver de ce plaisir
Il faut surtout éviter le contact prolongé entre les champignons et les matières plastiques. Mais le temps de peser, ça craint rien.
Oui, le carton dans un endroit bien aéré, ça devrait le faire. A l'abri de la lumière directe du soleil, c'est mieux.
Si t'as un ventilateur pour souffler dessus, c'est encore mieux.
Les premiers jours, une ou plusieurs couches de papier essuie-tout sous les champis devrait aider à absorber une partie de l'humidité par capillarité.
Si tu coupes les champignons longitudinalement, ça séchera plus vite, et tu pourras poster une photo pour vérifier qu'ils ne sont pas moisis à l'intérieur, comme on voit dans le lien ci-dessous.
https://www.psychoactif.org/forum/2023/ … .html#divx
C'est une bonne habitude de vérifier, mais t'inquiète pas hein, tout à l'air ok.
Tu peux les laisser sécher autant qu'il faut. Je dirais même "tu dois", car c'est très important pour bien les conserver. Sinon, ils risquent de moisir et de devenir inconsommables.
Un lien sur le séchage et l'homogénéisation d'une récolte. Mon post dans ce fil regroupe à peu près tout ce que je sais sur la question :
https://www.psychoactif.org/forum/2023/ … .html#divx
Amicalement.
PS : Tu peux me tutoyer hein ! C'est l'usage sur le forum. Ou alors je te vouvoie si tu préfères, mais ne restons pas dans ce déséquilibre, c'est un peu gênant
Daccord merci. Je vouvoie par habitude, on peut se tutoyer alors 
Il y a juste quelques taches sombres qui m’inquiète un peu je ne savais pas qu’il pouvait moisir de l’intérieur sans qu’on le voit
Comme sur cette photo, mais je pense que c’est l’endroit où j’ai mis mes doigts pour la récolte.
Peuvent-ils moisir aussi pendant le séchage ? Où tout se passe avant la récolte
Merci pour les liens, je vais lire tout ça
Hors ligne

C'est normal les traces bleues là où tu as mis les doigts, c'est l'oxydation.
La plupart des contas ont lieu avant la récolte, mais ça peut aussi moisir pendant le séchage si ta méthode est vraiment peu efficace.
Celui-ci m'inquiète un peu, le pied est vraiment noir. Tu peux nous en faire une coupe longitudinale ?
Hors ligne

Pesteux a écrit
C'est normal les traces bleues là où tu as mis les doigts, c'est l'oxydation.
La plupart des contas ont lieu avant la récolte, mais ça peut aussi moisir pendant le séchage si ta méthode est vraiment peu efficace.
Celui-ci m'inquiète un peu, le pied est vraiment noir. Tu peux nous en faire une coupe longitudinale ?
D’accord, ça me rassure. Merci
À l’intérieur, ça m’a l’air d’aller peut-être juste un peu noir, mais la photo fait plus sombre
Merci pour tes réponses aussi rapide
Hors ligne


Hors ligne

Pesteux a écrit
Arrivés à maturité, les champis changent très vite. En quelques heures, les voiles s'ouvrent, et les spores peuvent tomber. Pour récolter tous ses champis juste avant l'ouverture du chapeau, il faut les surveiller comme le lait sur le feu, vérifier plusieurs fois par jour, et faire plusieurs prélèvements dans la journée. Ca demande beaucoup d'attention, surtout si tu as plusieurs boxes.
T'as vraiment constaté qu'un lâcher de spores sur le substrat impactait négativement le flush suivant ? Franchement, ça fait quatre mois que j'ai une moyenne de 35 boites de 5 et 10 litres en colo-fruitaison, ce qui amène à un certain je-m'en-foutisme logistique, et que je laisse les chapeaux ouverts un ou deux jours le temps que les suivants rattrapent leur retard, ou que je fasse de la récolte progressive et extemporanée sur trois ou quatre jours, ça change que dalle une fois la trempette effectuée.
Après je dis pas, niveau concentration de psilocybine par mm cube de champi, c'est plus avantageux de récolter dès le voile déchiré, si on veut pas en bouffer plus que de raison, je me questionne uniquement sur le comportement reproductif des bestioles.
Dernière modification par Doromo (30 août 2023 à 20:59)
Hors ligne

Tu sais, je suis presque totalement novice en culture de champis. J'ai encore énormément de choses à apprendre. Ma copine et moi, on a acheté nos premiers kits l'hiver dernier, et on a réussir à faire plusieurs flushs seulement sur certains : les quelques-uns qu'on n'a pas cramés avec le tapis chauffant^^
Des vrais noobs quoi 
C'est clair qu'il y a de nombreux membres bien plus expérimentés et savants que moi sur la culture des champis. Tu en fait parti Doromo. Moi, je ne réponds qu'aux questions des débutants, pour aider au fonctionnement du forum dans la mesure de mes moyens. Les conseils que je donne, je les tiens de ma petite expérience (grandissante !) et des archives du forum. En particulier les posts de Daane-El, que je tiens à remercier.
Je sais qu'il y a polémique sur le sujet du lâcher de spore qui gène les flushs suivants ou non. Mais je n'ai aucun avis tranché sur le sujet, on a toujours réussi à cueillir avant ! Faudra quand même que je les laisse sporuler une fois, juste pour voir ce que ça donne...
Si je m'embête à récolter avant la sporulation, et que je conseille aux autres cultivateurs débutants d'en faire autant, c'est surtout pour d'autres raisons :
1/ Si le pain est tout noir, les contaminations sont plus difficilement détectables.
Ca me semble un argument de poids, surtout pour les débutants qui n'ont encore jamais vu de conta. Ne pas savoir si mes champis sont vraiment contaminés ou si je psychote, c'est vraiment une situation que je veux éviter. Devoir jeter mes champis "dans le doute", brrrrr, j'en frissonne d'horreur^^
Et pour demander des conseils en postant des photos sur le forum, ça va mieux avec des tofs les plus lisibles possible. Eviter la sporulation augmente les chances d'avoir une réponse pertinente.
2/ Si on laisse pousser le champignon après la sporulation, la concentration en psilocybine par gramme sec diminue, comme tu le mentionnes dans ton message.
Du coup, tous les conseils qu'on trouve sur le dosage sont faussés. On ne peut plus du tout se fier aux tableaux qu'on trouve sur le forum, que ça soit pour faire un trip ou du microdosing. Encore une fois, c'est surtout pour les débutants que c'est le plus gênant.
De plus, comme tu le dis, on doit en bouffer plus, et c'est pas forcement le meilleur moment du trip^^ Il parait aussi que c'est encore moins bon avec des spores, mais j'ai jamais testé.
Et pour terminer, cueillir tous ses champis exactement au même stade de leur croissance, c'est déjà commencer l'homogénéisation de la récolte. Et ça aussi, ça aide à avoir des repères pour le dosage.
En résumé, je dirais que pour une première fois, laisser sporuler les champis, c'est vraiment aller au devant de complications inutiles.
Maintenant, on n'a jamais eu plus que 4 boites en même temps, et on trouvait déjà que c'était le bordel à gérer, alors avec 35, je comprends que tu te sois pas aussi rigoureux que nous
C'est bon à savoir que tu t'en sors très bien comme ça. Il me semble que Sillycone avait lui aussi posté un témoignage pour relativiser le risque de conta des flushs suivants en cas de sporulation.
Ensuite, j'imagine que c'est pas la même chose si tu as juste un petit lâcher de spore d'un champi que t'as pas cueilli à temps Vs tu laisses tout pousser une semaine de trop et ton pain est entièrement recouvert de spores ! T'as l'air d'avoir trouvé un bon compromis, mais c'est ton expérience qui te permet ça.
Je pense qu'avec le temps, on peut se détendre sur la question. Mais pour commencer, il vaut mieux s'y prendre "by the book".
Dernière modification par Pesteux (31 août 2023 à 12:40)
Hors ligne

Dernière modification par Doromo (31 août 2023 à 14:48)
Hors ligne

35 boites en même temps, c'est vraiment impressionnant ! Et plusieurs journées de 6H pour s'en occuper, pffiouuu, ton enthousiasme fait plaisir à lire ! En fait, j'arrive même pas à me représenter les choses, je serai curieux de voir ton install, t'as pas des photos ?
Mais même à ma petite échelle, j'te comprends. D'abord parce que je trouve ça amusant de faire pousser des champis, et aussi parce que j'ai toujours peur de manquer. Là, on doit avoir dans les 300g de champis secs pour 2 ou 3 personnes, et on s'était juré qu'on en avait assez pour ne rien faire pousser cette année. Mais on va pas tenir, c'est trop tentant
On a trouvé un prétexte : essayer les Penis Envy pour tester si c'est vraiment plus potent que les Golden Teacher. (merci à Lapin Blanc pour m'avoir soufflé cette bonne excuse^^).
Vu les quantités que tu dois avoir, je serai intéressé de savoir comment tu envisages la conservation à long terme. J'avais fait un post là-dessus (ici), peut être que t'as des idées ou remarques à ajouter ?
Et aussi, que penses-tu de la technique de mettre de l'alu pour que ça pousse pas sur les coté de la boxe ? J'ai l'impression qu'alu ou non, ils poussent dès qu'il y a un espace vide entre le substrat et la boite. Pour le moment, on s'en accommode très bien, mais bon, j'suis curieux. J'ai toujours cru que les champignons s'en foutaient de la lumière puisque qu'ils ne fonctionnaient pas par photosynthèse.
Enfin bref, avec tout ce que t'as fait pousser, tu dois savoir des tas de trucs, et comme tu dis, le volume permet de faire des expériences pour buster les mythes. N'hésite pas à nous faire part de tes trouvailles, on sera nombreux à être intéressés :)
Amicalement.
Hors ligne

Pesteux a écrit
Et aussi, que penses-tu de la technique de mettre de l'alu pour que ça pousse pas sur les coté de la boxe ?
Sert à rien. Comme tu dis, c'est pas la lumière qui les fait pousser là plutôt qu'ailleurs.
J'ai fini par arriver à limiter au maximum les latéraux en alliant plusieurs techniques.
1) Le plus important : Créer un chemin de moindre résistance vers le centre du substrat à l'accouchement (je suis sur du coco/verm uniquement). Donc tasser davantage sur les bords de la boite, en diagonale vers le bas et vers le plastique, que partout ailleurs. Puis je saupoudre d'une fine couche de substrat, juste de quoi couvrir les grains, couche que j'humidifie ensuite au spray, en évitant de pchitter sur les bords, juste assez pour créer un différentiel d'humidité qui donne envie au mycélium de fruiter par là. Personnellement, je préfère utiliser un substrat plutôt sec, et une couche bien humide (ça colonise plus vite en plus), quitte à avoir un second flush plus gros que le premier, mais tout ce qui compte, c'est qu'il y ait une différence relative.
Une fois que c'est fait, je clipse les couvercles et je touche à rien du tout jusqu'aux premiers primordias, où je me contente de déclipser. S'il y a trop de condensation, et que les gouttes s'accumulent de trop, j'éponge une fois à la serviette en papier, mais rien de plus.
2) Travailler avec des souches un minimum sélectionnées plutôt que du multispores. Je trouve que toutes autres choses étant égales, plus la diversité génétique est limitée, plus le mycélium aura tendance à coopérer et à envoyer toutes ses ressources communes là où il est le plus facile de fruiter. Avant de se venger au second flush, parfois, mais bon ^^ Le multispores, c'est vraiment la sédition totale, chacun délire dans son coin, connards d'individualistes. Et puis chacun à son propre planning et tout, la galère.
3) Accepter les lats (mon surnom pour les side-pins). Honnêtement, c'est relou si y en a plein, mais un ou deux par ci par là, on pose la boite debout sur un bord, on retient le pain avec un doigt, on cueille les dissidents (discroissants pour le coup) de l'autre main, et hop. Et les petits, on les laisse, osef. Ils deviennent velus de mycelium après la trempette, c'est pas bien gênant. Et quand t'y penses, ça augmente la surface de rendement (et une fois le pain bien contracté, les lats poussent verticalement, jusque par dessus la couche superficielle, et deviennent faciles à cueillir).
Là, on doit avoir dans les 300g de champis secs pour 2 ou 3 personnes, et on s'était juré qu'on en avait assez pour ne rien faire pousser cette année. Mais on va pas tenir, c'est trop tentant
Franchement, je sais pas combien vous consommez, mais 100g par personne dans l'année, c'est vraiment pas si large, donc yeah Penis Envy. Dites bonjour à Freud de ma part quand vous tripperez avec.
J'avais fait un post là-dessus (ici), peut être que t'as des idées ou remarques à ajouter ?
Ma technique est assez proche. Champis entiers (parfois ouverts longitudinalement pour les plus mous, les albinos surtout) au déshydrateur 24h à 70C, puis je broies grossièrement dans un mortier (je cherche juste à aplatir pour réduire les risques de déchirure des sachets ensuite), puis j'ensachète sous vide par 10-16 g, puis je mets les sachets dans des bocaux en verre hermétique, avec un sachet de gel de silice ou deux (avec indicateur), le tout dans un fond de placard, avec le reste de mes trésors.
Je verrai bien si ça fonctionne dans quelques années. Au pire, ce sera l'excuse pour ressortir les empreintes de spores et la boite à air. Et si je me fais des amis fongivores dans mon coin, je pourrai écouler mes kilos avec eux sans me sentir juste.
"En fait, j'arrive même pas à me représenter les choses, je serai curieux de voir ton install, t'as pas des photos ?"

C'était lors de la première vague. Imagine la même plus une étagère noire et une autre blanche, et plus aucune place sur aucune d'elles (l'étage du bas restant vide pour les noires, trop proche du sol à mon gout). Pas mécontent d'en voir le bout (et maintenant faut résoudre le problème du séchage/curage de mes plans screugneugneu). Aussi, j'ai une fenêtre d'un côté, orientée plein nord, j'ouvre les volets à 10 heures du mat. C'est tout. J'ai vu une petite amélioration pendant la période où j'allumais la lampe bleu du plafond quelques heures par jour, et certaines souches adorent la lumière, d'autre moins. En tout cas, je mets tout dans les mêmes conditions climatique, j'ai juste un radiateur pour si les températures descendent en dessous de 20C durablement en journée, mais sinon, c'est balek.
Tiens, cadeaux des derniers jours, pour le plaisir des yeux :




Les monstrueux albinos. Plus elles sont grandes plus elles sont molles.
(les chouettes, ça a toujours l'air Agar)
Ah, possible que je fasse appel à tes talents de mycologue de terrain quand j'irai à la cueillette de lancéolés cet automne ^^
Dernière modification par Doromo (07 septembre 2023 à 21:20)
Hors ligne

[EDIT] : D'un coup, je réalise que de fil en aiguille, on est partit complètement hors sujet par rapport aux questions de Waiii sur sa culture. Désolé pour ça, on reste dispo pour répondre à tes questions dès que tu nous donnes des nouvelles ! Ils étaient comment alors tes autres champis ?
[/EDIT]
Merci pour ton retour Doromo !
Je suis plein d'admiration. Et aussi un peu jaloux^^ Ton install fait envie, c'est breaking bad at home version bio
Et puis ces forêts de champis, c'est tellement beauuuuu...
J'étais tellement impressionné que j'en ai fait une horrible faute de frappe en te champignonnant ! Et je peux même pas éditer...
On en est encore aux boxes pour quelques années je pense, mais on se lancera forcément un jour ou l'autre !
Doromo a écrit
Sert à rien. Comme tu dis, c'est pas la lumière qui les fait pousser là plutôt qu'ailleurs.
Ahhhh, jm'en doutais, mais ça fait du bien d'avoir une confirmation !
Doromo a écrit
J'ai vu une petite amélioration pendant la période où j'allumais la lampe bleu du plafond quelques heures par jour, et certaines souches adorent la lumière, d'autre moins.
Des noms, des noms !
Doromo a écrit
Le multispores, c'est vraiment la sédition totale, chacun délire dans son coin, connards d'individualistes. Et puis chacun à son propre planning et tout, la galère.
Mdr
J'adore ce genre de formulation ! C'est vraiment agréable à lire cette légèreté :)
Doromo a écrit
Franchement, je sais pas combien vous consommez, mais 100g par personne dans l'année, c'est vraiment pas si large, donc yeah Penis Envy. Dites bonjour à Freud de ma part quand vous tripperez avec.
Lol, avec un peu de chance, rien que le nom des champis, ça va orienter les trips
En vrai, nous-mêmes, on ne sait pas encore très bien combien on va consommer. On expérimente ça sérieusement (hum) depuis l'automne dernier seulement.
Au début on se disait : 300g, ça fait quand même 20 trips à 5g secs chacun ! Une dose dite héroïque encore jamais atteinte pour le moment.
Mais on n'arrête pas de revoir notre conso à la hausse 
Déjà, on a augmenté les doses progressivement, histoire de se familiariser avec l'effet. Et cet été, on a testé nos Cubensis pour les comparer à nos Semilanceatas. Alors on a pris des plus petites doses pour être prudent les premières fois, et aussi parce que c'était nos premiers trips en extérieur. Ben on s'est rendu compte que les petites doses qui nous avaient enthousiasmées la première fois, on les trouvait frustrantes maintenant, et qu'on n’avait pas envie de revenir en arrière sur les doses. Une première raison de prévoir plus large.
En plus, on est de passé de tous les mois à toutes les deux semaines, pour profiter au max des trips en pleine nature tant que le beau temps le permettait. Et maintenant, on est bien tentés de maintenir ce rythme^^ (voir plus souvent à l'occasion, si notre tolérance nous le permet). Ca fait déjà conso x2 !
Ca devrait encore aller pour cette année je pense. Mais c'est vrai que plus l'expérience s'accumule, plus on prend confiance, et plus on a envie d'aller voir plus loin. Et donc, plus on se sent juste. C'est pas addictif au sens physique du terme, mais c'est vrai qu'on y prend goût^^
T'en consommes combien toi ?
Doromo a écrit
au déshydrateur 24h à 70C
Pourquoi si chaud ? Pourquoi flirter avec la température de dégradation de la psilocybine ? Ca marche aussi bien à 40°C, non ? (quitte à laisser 48H) J'ai loupé un truc ?
Doromo a écrit
puis je broies grossièrement dans un mortier (je cherche juste à aplatir pour réduire les risques de déchirure des sachets ensuite)
Pas con du tout ça : ça m'est déjà arrivé de me rendre compte qu'un sachet s'était rempli d'air. J'ai jamais trouvé le trou. J'ai cru à une mauvaise soudure, mais si ça se trouve, c'est un morceau de champignon séché un peu pointu qui a fait une micro déchirure dans le sachet. Vandale ! J'en étais presque à douter de la pertinence du conditionnement sous vide (un leparfait avec un absorbeur d'oxygène, au moins, ça se perce pas).
Doromo a écrit
Ah, possible que je fasse appel à tes talents de mycologue de terrain quand j'irai à la cueillette de lancéolés cet automne ^^
Ca sera avec grand plaisir.
D'ailleurs, ton message m'a donné envie de rassembler mes photos de sem pour te les montrer, et finalement, j'en ai fait un tuto :
https://www.psychoactif.org/forum/viewt … 98#p638298
Ensuite, le plus dur, ça va pas être de les reconnaître (j'te sens quand même bien débrouillard comme gars), mais de trouver un spot. T'as intérêt à aimer la nature et les balades dans les champs, sinon tu risques de te décourager avant d'avoir trouvé. Ou alors, ça va te faire comme moi, tu vas tomber amoureux de la nature de ton coin.
Si tu pars de 0, je te conseille de te familiariser avec le site geoportail.fr : le combo carte IGN et photos aériennes, ça aide bien dans les recherches. Et c'est une toute autre qualité cartographique que google map. Un GPS capable d'enregistrer un point t'intérêt pour y revenir plus tard, c'est pas mal non plus. Et ça aide à retrouver la voiture quand on est surpris par la nuit (on ne la voit pas arriver quand on a les yeux rivés au sol toute la journée, et on a vite fait de se perdre). Une bonne lampe à LED, ça aide aussi.
De mon côté, ma conso étant assurée par les boxes (ouais j'y crois encore^^), je vais prendre le risque de revenir les mains vides, et partir à la recherche de nouveaux spots, plutôt que de retourner tout piller sur les quelques endroits que je connais déjà. Mais c'est une décision difficile à prendre^^
Mais mes meilleurs spots, je les ais trouvé totalement par hasard. A chaque fois, sur des chaumes Vosgiennes qui n'avaient pas été engraissées ni labourées depuis plusieurs décennies au moins (avec vaches, mais pas tous les ans, et/ou coupe de l'herbe très raisonnable, juste le minimum pour que la chaume ne devienne pas forêt).
Je te souhaite bonne chance dans ta quête. Quelle jubilation quand tu trouves un coin où ils poussent en abondance :p
Une belle cueillette, 755 champis : 
Amicalement.
Dernière modification par Pesteux (12 septembre 2023 à 18:05)
Hors ligne

Pesteux a écrit
Et puis ces forêts de champis, c'est tellement beauuuuu...
Ouuuuiiiiii et je les aiiiiime mais qu'est-ce que ça prend comme teeeeeemps.
Pesteux a écrit
Des noms, des noms !
Les albinos sont les plus héliophiles du lot, genre ils vont tous pousser à l'horizontale vers la fenêtre s'ils sont placés en hauteur. Les B+ et les Thai aussi, mais c'est moins flagrant. Les autres s'en tamponnaient pas mal. Mais bon, il y a fort à parier que si j'avais continué de dupliquer/sélectionner une souche d'albinos, j'aurais pu tomber, par loterie génétique, sur un mycélium héliofuge, à force. T'as même des albinos qui finissent par reprendre des couleurs ^^
Pesteux a écrit
Pourquoi si chaud ? Pourquoi flirter avec la température de dégradation de la psilocybine ? Ca marche aussi bien à 40°C, non ? (quitte à laisser 48H) J'ai loupé un truc ?
Justement, j'avais pas envie de laisser 48h. Ne serait-ce que pour ne pas créer de bouchon dans mon frigo (fallait enchainer, charrette charrette). En vrai, quand on se prend une tisane à la psilocybine, on monte à des température proches de 100C sans souci. Ajouté au fait que quasi tous les cultivateurs, sur Shroomery, chauffent à 75C, et c'est pas ceux qui trippent le moins, je vois pas de raison de sous-chauffer, tant que l'air chaud n'est pas stagnant comme dans un four, y a pas de problème. Mais oui, ça marche très bien à 40.
Mais on n'arrête pas de revoir notre conso à la hausse
Ahah, classique. En même temps, si vous avez des affinités pour les champis, le temps et l'endroit de voyager régulièrement, faut pas se priver. Vous aimez faire quoi pendant vos trips ? Ballade en nature et advienne que pourra ?
"T'en consommes combien toi ?"
Un trip à 6/7g par semaine, parfois précédé de 260mg d'harmala-freebase quand je me sens juste d'humeur à me dissoudre dans la mousse quantique en oscillant dans mon hamac, plutôt que de laisser mon corps s'agiter comme un possédé ou retomber sans cesse en contemplation devant la nature. Le deuxième trip hebdomadaire, c'est quelques douilles de changa en forêt au crépuscule, pour regarder les démons s'extirper de mon ombre et s'ébattre dans le paysage.
Ça suffit à me calmer, globalement, et à repousser la trompeuse nostalgie des cauchemars mystagogiques à la DMT. Les champis peuvent m'emmener où ils veulent, mais Domitille sans son pote Harmin, elle me fait vraiment pas du bien, et j'oublie constamment pourquoi quand j'arrête d'en prendre ^^°
T'as intérêt à aimer la nature et les balades dans les champs, sinon tu risques de te décourager avant d'avoir trouvé. Ou alors, ça va te faire comme moi, tu vas tomber amoureux de la nature de ton coin.
J'ai que des champs de vaches en agriculture extensive, blottis entre des parcelles forestières qui masquent bien la vue, majoritairement pins et fougères, donc le PH du sol doit être propice, je devrais pouvoir me faire plaisir. Je suis vraiment curieux des effets des lancéolés, j'ai jamais testé, mais j'ai cru comprendre qu'ils étaient assez différents, non ?
Ta récolte est magnifique @_@ Ils sont vraiment choupis nos champis endémiques. Il en faut un bon bouquet par trip, j'imagine.
Dernière modification par Doromo (13 septembre 2023 à 12:52)
Hors ligne